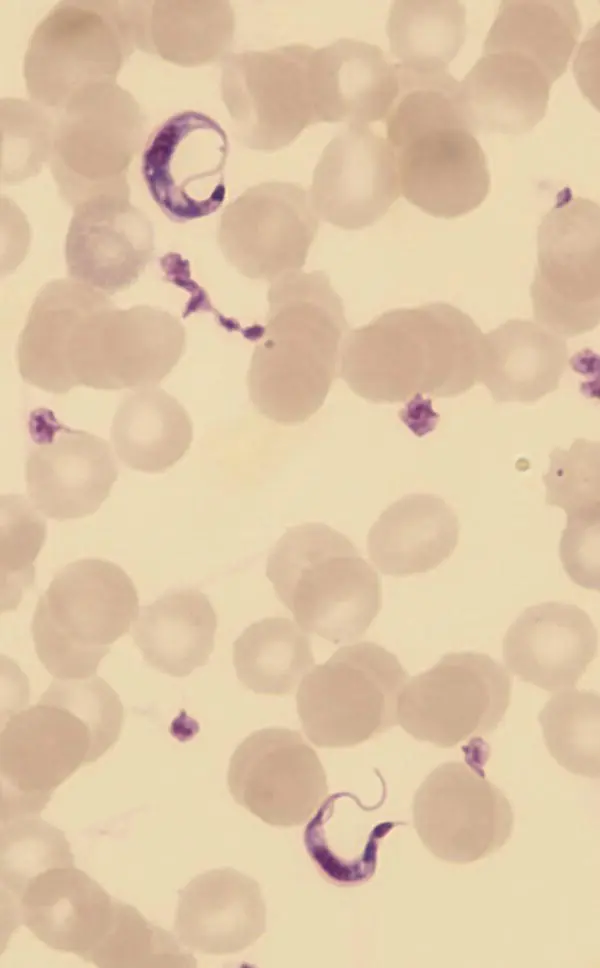
Figure 410 Trypanosoma cruzi Note the characteristic C shape often seen in - фото 35

Alan Gunn - Parasitology
Здесь есть возможность читать онлайн «Alan Gunn - Parasitology» — ознакомительный отрывок электронной книги совершенно бесплатно, а после прочтения отрывка купить полную версию. В некоторых случаях можно слушать аудио, скачать через торрент в формате fb2 и присутствует краткое содержание. Жанр: unrecognised, на английском языке. Описание произведения, (предисловие) а так же отзывы посетителей доступны на портале библиотеки ЛибКат.
- Название:Parasitology
- Автор:
- Жанр:
- Год:неизвестен
- ISBN:нет данных
- Рейтинг книги:3 / 5. Голосов: 1
-
Избранное:Добавить в избранное
- Отзывы:
-
Ваша оценка:
- 60
- 1
- 2
- 3
- 4
- 5
Parasitology: краткое содержание, описание и аннотация
Предлагаем к чтению аннотацию, описание, краткое содержание или предисловие (зависит от того, что написал сам автор книги «Parasitology»). Если вы не нашли необходимую информацию о книге — напишите в комментариях, мы постараемся отыскать её.
Highly detailed textbook on parasites and parasite relationships Parasitology: An Integrated Approach
Parasitology: An Integrated Approach, 2nd edition
Parasitology — читать онлайн ознакомительный отрывок
Ниже представлен текст книги, разбитый по страницам. Система сохранения места последней прочитанной страницы, позволяет с удобством читать онлайн бесплатно книгу «Parasitology», без необходимости каждый раз заново искать на чём Вы остановились. Поставьте закладку, и сможете в любой момент перейти на страницу, на которой закончили чтение.
Интервал:
Закладка:
The life cycle of T. cruzi differs from that of the other trypanosome species discussed so far in that it involves stercorarial transmission from the invertebrate vector to the vertebrate host (i.e., via the faeces rather than the saliva/bite). Reduviid bugs often defecate during or immediately after feeding, and they void the infective metacyclic stage trypanosomes with their faeces. The bugs feed at night and they often bite their victims around the face. They have therefore gained the common name of kissing bugs. On waking, the natural reaction is to rub/scratch at the bite site, and this rubs the parasite‐infected faeces into the wound site. However, most infections result from bug faeces contaminating the victim’s fingers and from there transferring to the eyes and mucous membranes where the parasites can penetrate more easily. We can also become infected from organ transplants and the use of contaminated blood during transfusions (Ries et al. 2016). In endemic areas, where the likelihood of acquiring T. cruzi infection from a blood transfusion is high, haematologists sometimes treat donated blood with gentian violet. This kills the parasites, but as the blood infuses through the tissues of the recipient, it also has the unfortunate effect of turning the patient purple temporarily. There are isolated reports of oral transmission of T. cruzi that date back many years. These arise through consuming food contaminated with infected bug faeces. They were considered rare oddities, but this mode of transmission is apparently becoming more common (Robertson et al. 2016). Furthermore, oral transmission tends to result in acute infections that may prove rapidly fatal. Congenital infection via the placenta is possible and can result in spontaneous abortion or serious disease of the infant at birth. Reservoir animals can acquire infections through being bitten, as well as from consuming bugs containing the parasites and from food contaminated with their faeces.
Once T. cruzi enters a suitable mammalian host, the trypomastigotes invade both phagocytic and non‐phagocytic cells. Indeed, they are apparently capable of invading all nucleated cells. However, most of the pathology arises from their invasion of smooth, cardiac, and skeletal muscle cells, nerve cells, and cells comprising organs such as the liver, spleen, and lymphatics. Within a host cell, the parasites develop within a parasitophorous vacuole. The mechanism by which a trypomastigote enters a host cell varies between cell types and may involve active invasion by the parasite and passive internalization through endocytosis/phagocytosis. Within the host cell, a parasitophorous vacuole forms around the parasites and within this, they transform into the amastigote stage (1.5–4 μm in size). The amastigotes multiply by binary fission and once large numbers are present within a cell, it is sometimes referred to as a pseudocyst. Eventually, the parasites kill their host cell and then they transform back to trypomastigotes ( Figure 4.10). The trypomastigotes then invade new cells and repeat the process. This distinguishes T. cruzi from Leishmania in which the parasites occur mainly within phagocytic cells and remain in the amastigote stage within the vertebrate host. The trypomastigotes of T. cruzi are unable to reproduce although large numbers of them may occur in the blood stream, especially during the early stages of infection. Broad and slender morphotypes of the trypomastigotes exist. Both forms are small (16.3–21.8 μm in length including the flagellum) compared with those of some other trypanosomes and they have a characteristic curved ‘C’ shape. By contrast, their kinetoplast is exceptionally large and the cell membrane sometimes bulges around it.
Figure 4.10 Trypanosoma cruzi . Note the characteristic C shape often seen in the trypomastigote stage.
A reduviid bug vector acquires an infection when it feeds on blood containing the trypomastigote stage. Reduviid bugs can take in large blood meals several times their own body weight, and this increases their chances of ingesting a trypomastigote. In some bug populations, over half of them carry a T. cruzi infection. In addition to feeding on blood, reduviid bugs will also attack and feed on one another. Therefore, bugs may acquire an infection by ingesting parasites from one of their brethren. However, this is probably not a common means of infection. When the parasites reach the posterior of the insect’s midgut, they transform into short epimastigotes. These then divide by longitudinal fission to form long epimastigotes. Ultimately, the epimastigotes move to rectum where they transform into the infective short metacyclic trypomastigote stage. The gut of infected bugs can contain huge numbers of parasites but unlike some of the other trypanosome species, T. cruzi does not appear to harm its invertebrate host.
The course of Chagas disease varies considerably, and there are marked disparities between individuals and geographic localities. This suggests that genetic differences on the parts of both the parasite and the host influence the manifestation of disease. There are two phases of the disease: an acute phase and a chronic phase. Initial parasite invasion may cause an acute infection or symptoms so general that it is not obvious that infection has occurred. The acute phase is characterised by high levels of parasitaemia and in a small percentage of cases proves fatal. There is often an initial localised inflammatory response with swelling of the nearest lymph node. If the infection starts at an insect bite wound, a raised red nodule develops called a ‘chagoma’. If the infection occurs via the eye, it induces a condition called Romaňa’s sign in which the eyelid and preauricular lymph node swell so much that the eye becomes closed. As the acute phase of the disease progresses, the parasites invade all organs of the body. However, the most severe consequences arise from the parasite’s tendency to localise within and destroy heart muscle and cardiac ganglion cells. The pathological mechanisms are uncertain. However, damage to cardiac muscle during chronic Chagas disease may have an autoimmune basis. As he became older, Charles Darwin suffered from chronic ill health, the symptoms of which were consistent with him suffering from Chagas disease. Obviously, it is impossible to confirm this, but in his South American journals he recorded being bitten by reduvidid bugs. If the parasites invade the brain, meningoencephalitis can develop with potentially fatal or long‐term damage as a result. The patient often develops a fever and their liver and spleen become enlarged; they may also suffer from diarrhoea and exhibit evidence of respiratory infection. The acute phase occurs most commonly in children less than 5‐years‐old but unless their heart or nervous tissues are severely damaged, most of them recover even without adequate medical treatment.
4.3 Phylum Chlorophyta
Commonly known as the green algae, the Chlorophyta is a paraphyletic phylum – that is, the species within it derive from several different ancestors. Because most of them contain chloroplasts, they are often referred to as plants. Furthermore, these chloroplasts are similar in appearance to those in multicellular plants, such as wheat and roses, have a very similar physiology, and contain both chlorophyll a and chlorophyll b. However, the Chlorophyta are single‐celled organisms (although some are colonial) and are usually classed within the Protista rather than Plantae – although this remains a source of debate. Several species have close symbiotic relationships with invertebrates. For example, Chlorella spp. lives in association with the cnidarian Hydra viridis, and some sea slugs extract the chloroplasts from their algal food and utilise them as photosynthetic organelles within their own cells. Although various algae grow on the pelage of sloths and the skin of certain lizards, there are few reports of them becoming intracellular symbionts of vertebrates. An instance where it does occur is between the alga Oophila amblystomatis and the egg masses of certain amphibia. This alga enters the embryos of the spotted salamander Ambystoma maculatum and is maternally transmitted (Kerney et al. 2019). The alga utilises nitrogenous waste generated by the host cells and undertakes photosynthesis; the relationship therefore appears to be beneficial to both organisms. The alga Nannochloris eukaryotum will enter an endosymbiotc relationship with human cells under in vitro culture conditions. However, this is mainly of interest for the development of molecular machines (Black et al. 2014) and not something that happens naturally outside the laboratory.
Читать дальшеИнтервал:
Закладка:
Похожие книги на «Parasitology»
Представляем Вашему вниманию похожие книги на «Parasitology» списком для выбора. Мы отобрали схожую по названию и смыслу литературу в надежде предоставить читателям больше вариантов отыскать новые, интересные, ещё непрочитанные произведения.
Обсуждение, отзывы о книге «Parasitology» и просто собственные мнения читателей. Оставьте ваши комментарии, напишите, что Вы думаете о произведении, его смысле или главных героях. Укажите что конкретно понравилось, а что нет, и почему Вы так считаете.












